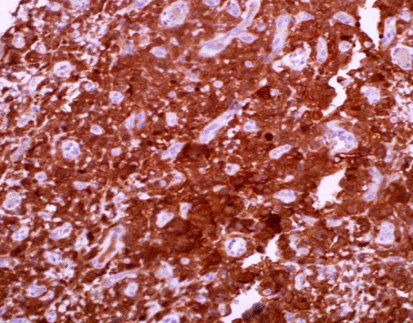

PRODUCT CATEGORY
PRODUCT CATEGORY
CONTACT US
C4d
C4d is a stable component that is covalently bound to endothelial cells and basement membrane, and the main production pathway is classical antibody-induced complement activation.This component can be detected in chronic rejection of kidney transplantation, hyperacute rejection, acute vascular rejection, acute cellular rejection and borderline rejection, and it is an indicator for the treatment of acute rejection.
Staining Tissue
- As Figure shows:
Palate tissue stained with C4d Polyclonal
Specification
|
CODE |
WORKING SOLUTION |
|||
|
CCR-0141 |
SPECIFICATION |
1ml |
3ml |
6ml |
More Info
Clone: Polyclonal
Source: Rabbit
Localization: Cytoplasm
Pretreatment: Thermal remediation
Applicable tissue: Paraffin section
Related Product














 Chat
Chat

 message
message

 Quote
Quote